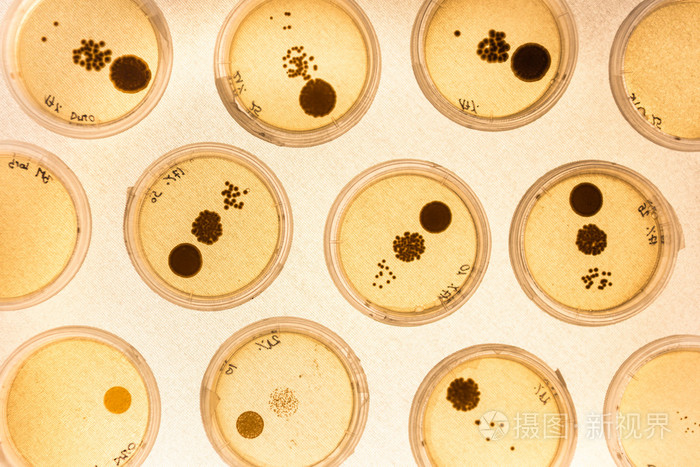
生长在培养皿中的细菌

细菌生长

最新2细菌生长繁殖护理精选ppt文档
图片尺寸920x690
生长在培养皿中的细菌
图片尺寸700x467
显微镜下在水里生长的退伍军人病菌.纽约市卫生局提供
图片尺寸500x400
肠道菌群详解小肠细菌过度生长sibo上篇
图片尺寸1080x617
细菌生长图片
图片尺寸300x300
细菌生长图片
图片尺寸450x300
对称生长的细菌
图片尺寸700x700
4册细菌的生长硬皮有声绘本肚子里有虫子吗伤口为什细菌成长系列
图片尺寸800x800不同的细菌和霉菌菌落生长在营养琼脂上
图片尺寸1200x800
细菌生长繁殖的条件
图片尺寸751x2001
细菌的生长表现形态学观察实验-微检员培训.
图片尺寸1080x810
测量小知识如何通过测量参数控制细菌生长上
图片尺寸1080x742
细菌的生长曲线
图片尺寸1080x810
细菌的生长
图片尺寸700x700
细菌生长图片
图片尺寸450x300
对称生长的细菌
图片尺寸700x700不同的细菌和霉菌菌落生长在有营养琼脂的培养皿上
图片尺寸1200x795
细菌真菌,生长繁殖,念珠菌
图片尺寸712x376
细菌生长图片
图片尺寸450x300
防止小肠细菌过度生长照片
图片尺寸300x300